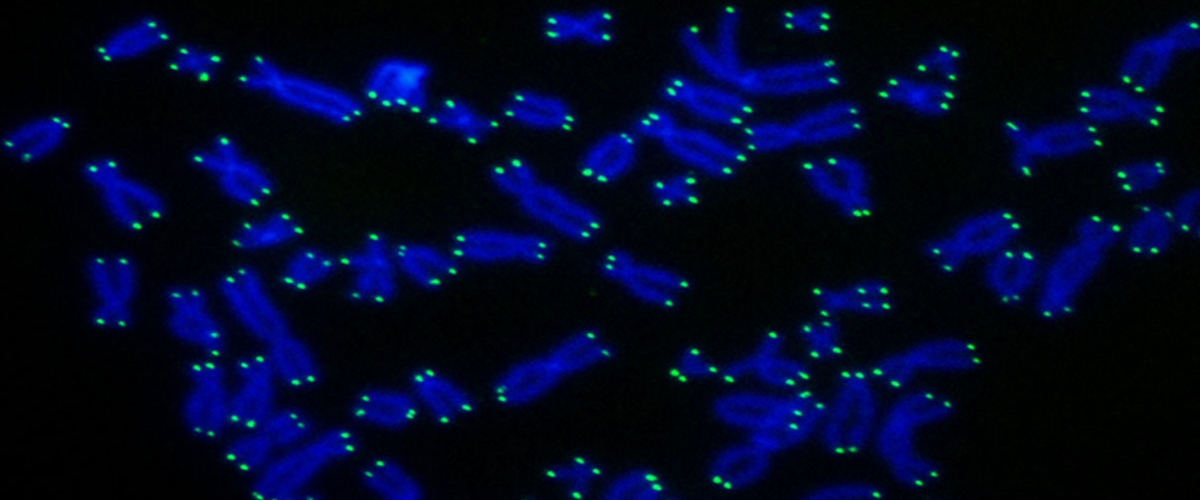
image

Как длина теломер защищает от рака: новое исследование ученых
Знаете ли вы, что у наших клеток есть встроенный лимит делений? В среднем здоровые клетки могут поделиться около 50 раз, и в этом им помогают теломеры — защитные «колпачки» на концах хромосом. С каждым делением они чуть-чуть укорачиваются, а когда иссякают полностью, клетка перестает размножаться. Интересно, что эту систему несколько десятилетий назад рассматривали как природную защиту от рака. И вот новое исследование из Рокфеллерского университета, кажется, подтверждает эту смелую идею.
Согласно гипотезе, после 50-го деления опухолевой клетки истощённые теломеры должны были бы поставить раку шлагбаум. Но опухоль — хитрая штука. Она может выжить, если её клеткам удастся «включить» особый фермент — теломеразу, который достраивает теломеры заново. По сути, это биологическое бессмертие, и оно смертельно опасно.
Раньше учёные выяснили, что большинство видов рака как раз и выживают благодаря повторной активации теломеразы, часто через мутации. Другие данные намекали, что укорочение теломер и правда может работать как противораковый барьер. Но здесь есть один критически важный нюанс.
Всё работает только если человек родился с «правильной» длиной теломер. Если они от природы слишком длинные, то их резерв не успеет истощиться вовремя, чтобы остановить опухоль. Получается, генетическая лотерея начинается прямо с рождения?
Учёные давно искали способы контролировать длину теломер. Они обнаружили набор белков, которые в этом участвуют. Один из ключевых игроков — белок TIN2. Если его заблокировать, теломераза начинает работать активнее, и теломеры удлиняются. Но что, если в самом гене, кодирующем TIN2, есть ошибка?
Ответ на этот вопрос пришёл из неожиданного источника — наблюдений за семьями с высокой наследственной предрасположенностью к раку. Оказалось, что у их членов есть мутации в гене TINF2, ответственном за производство белка TIN2.
Дальнейший анализ показал поразительную вещь: теломеры у этих пациентов были необычно длинными, но при этом функциональными. В истории их семей фигурировали колоректальный рак, меланома, опухоли щитовидной железы и другие онкологические заболевания.
«Предотвратить у них развитие болезни могли бы механизмы по укорочению теломер, однако этого не происходило из-за нарушений в работе супрессора теломер», — заключили исследователи. Выходит, сломанный «тормоз» для теломер может быть фатальным подарком по наследству.
Управление длиной теломер остаётся одной из самых интригующих головоломок в биологии. Новые открытия позволяют по-другому взглянуть на истоки рака и сами процессы старения. Кстати, другие учёные, например из Гарварда, экспериментируют с восстановлением длины теломер, пытаясь обратить вспять клеточное старение. А ещё известно, что некоторые болезни и даже регулярное потребление ультрапереработанной пищи укорачивают теломеры, приближая старость. Так что наше долголетие и здоровье действительно могут начинаться на самых кончиках наших хромосом.










